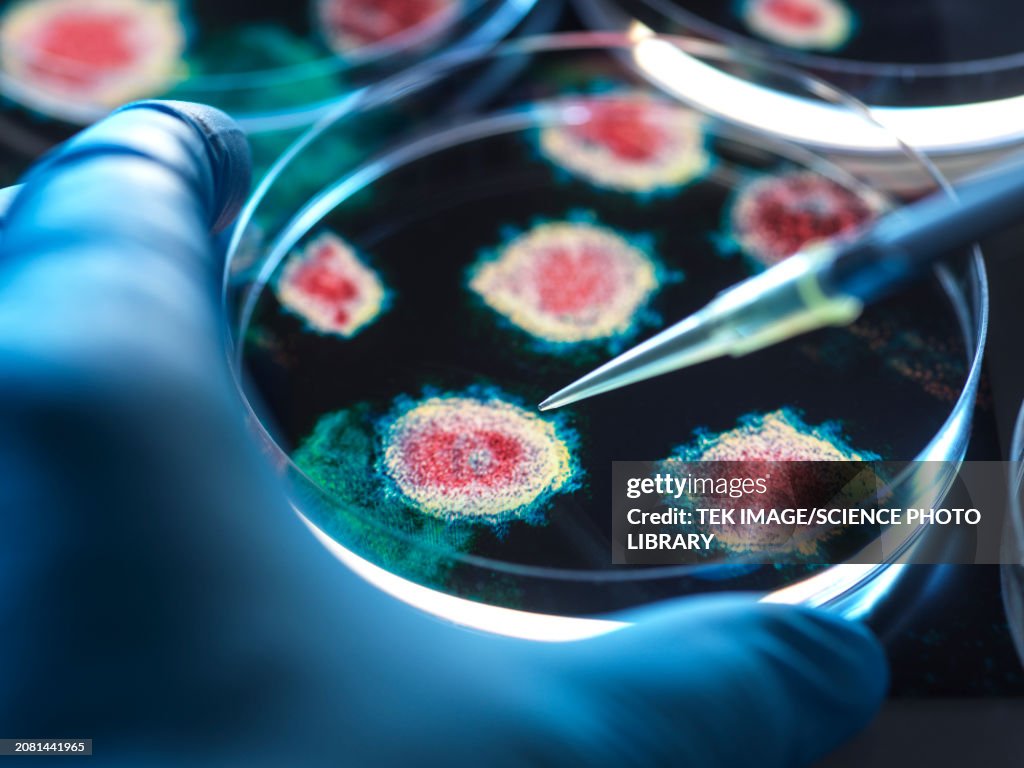

Virus research, conceptual image - Stock-Fotografie
Virus research, conceptual image. Scientist pipetting a substance into a petri dish with an electron micrograph of a virus in the background

Sichern Sie sich dieses Bild in einem von vielen Rahmen auf Photos.com.
EINE LIZENZ KAUFEN
Alle Lizenzen für lizenzfreie Inhalte beinhalten weltweite Nutzungsrechte, umfangreichen Schutz und eine einfache Preisgestaltung mit Mengenrabatten
335,00 €
EUR
Getty ImagesVirus Research Conceptual Image, Stock-Foto Laden Sie authentische Premium-Fotos zum Thema Virus research, conceptual image von Getty Images herunter. Entdecken Sie ähnliche hochauflösende Fotos in unserem umfangreichen Bildkatalog.Product #:2081441965
Laden Sie authentische Premium-Fotos zum Thema Virus research, conceptual image von Getty Images herunter. Entdecken Sie ähnliche hochauflösende Fotos in unserem umfangreichen Bildkatalog.Product #:2081441965
Laden Sie authentische Premium-Fotos zum Thema Virus research, conceptual image von Getty Images herunter. Entdecken Sie ähnliche hochauflösende Fotos in unserem umfangreichen Bildkatalog.Product #:2081441965
Laden Sie authentische Premium-Fotos zum Thema Virus research, conceptual image von Getty Images herunter. Entdecken Sie ähnliche hochauflösende Fotos in unserem umfangreichen Bildkatalog.Product #:2081441965335€50€
Getty Images
In stockDETAILS
Bildnachweis:
Creative #:
2081441965
Lizenztyp:
Kollektion:
Science Photo Library
Max. Dateigröße:
6000 x 4500 px (50,80 x 38,10 cm) - 300 dpi - 11 MB
Hochgeladen am:
Ort:
United Kingdom
Releaseangaben:
Mit Model-Release
Kategorien:
- Corona-Virus,
- Virus,
- Petrischale,
- Epidemie,
- Forschung,
- Krankheitserreger,
- Virologie,
- Labor,
- Analysieren,
- Ansteckende Krankheit,
- Gesundheitswesen und Medizin,
- Biotechnologie,
- Mikroorganismus,
- Fotografie,
- Innovation,
- Medikament,
- Menschen,
- Pipette,
- 60-64 Jahre,
- Alter Erwachsener,
- Biologie,
- Ein Mann allein,
- Eine Person,
- Einzelner Senior,
- Elektronenmikroskopische Aufnahme,
- Erwachsene Person,
- Farbbild,
- Horizontal,
- Krankheitsverhinderung,
- Mikrobiologie,
- Männliche Person,
- Nur Erwachsene,
- Nur Männer,
- Senioren - Männer,
- Vereinigtes Königreich,
- Weiße Abstammung,